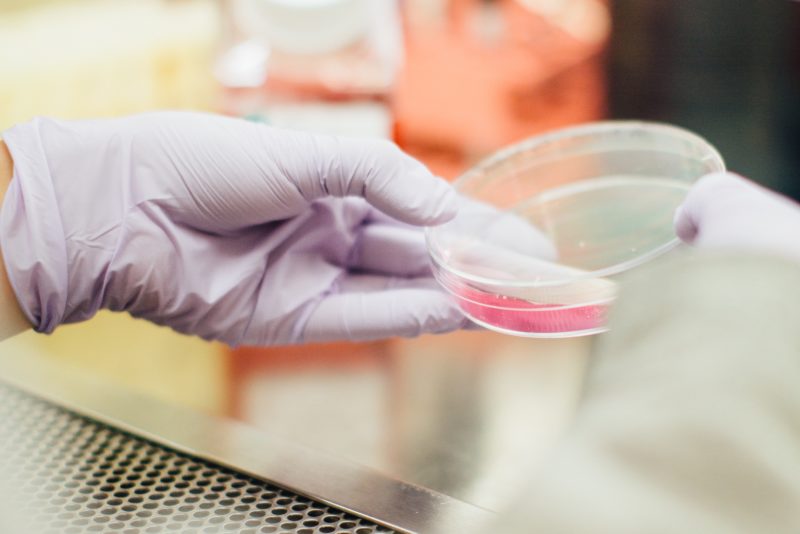

Ny guidebok om användning av alkohol- och drogtester
Företagshälsan har släppt en praktisk guidebok om säkra rutiner vid användning av alkohol- och drogtester.
Sveriges Företagshälsor – företagshälsovårdens branschorganisation – strävar efter att landets arbetsgivare ska få hållbara, effektiva och attraktiva organisationer. Medarbetare ska samtidigt få ett hälsosamt, säkert och stimulerande yrkesliv.
Den nya guiden ”Företagshälsans guide för kvalitetssäkrad alkohol- och drogkontroll i arbetslivet” syftar till att beskriva hur arbetsplatsen i samverkan med företagshälsan på bästa sätt kan kvalitetssäkra genomförandet av alkohol-och drogtestning i arbetslivet. Löpande i texten finns tydliga sammanfattningar som gör det enklare att ta till sig de viktiga delarna.
Här hittar du guiden i sin helhet.



